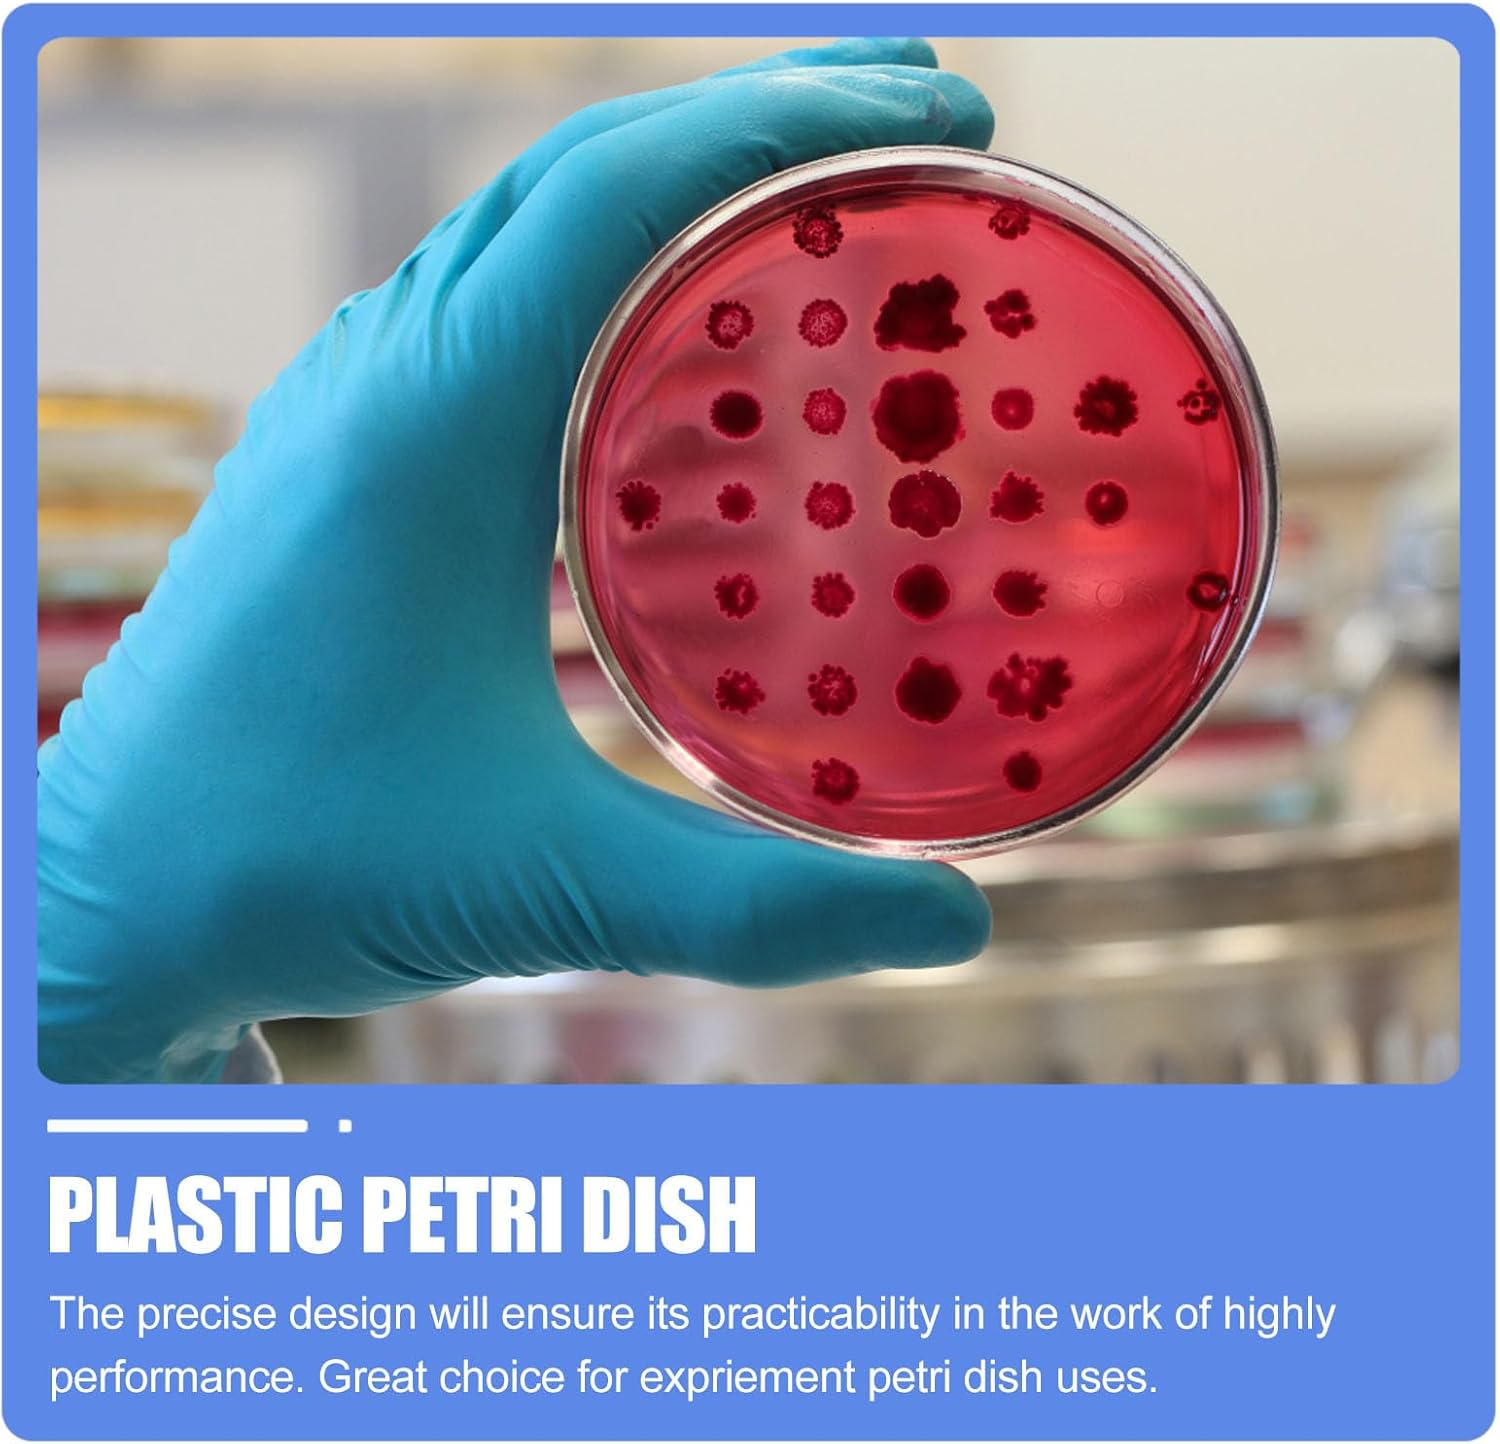
Plastic Petri Dishes with Lid - 20Pcs Agar Plates, Clear Empty Dish for School Science Project Microorganisms Cell Yeast - Petri Dishes with Lid Bulk Suite - 70Mm X 15Mm image number 1

Plastic Petri Dishes with Lid - 20Pcs Agar Plates, Clear Empty Dish for School Science Project Microorganisms Cell Yeast - Petri Dishes with Lid Bulk Suite - 70Mm X 15Mm


Plastic Petri Dishes with Lid - 20Pcs Agar Plates, Clear Empty Dish for School Science Project Microorganisms Cell Yeast - Petri Dishes with Lid Bulk Suite - 70Mm X 15Mm
- Practical agar plate: thickened design and high transparency, not only not easy to damage but also good for observation in experiments such as culturing cells
- Excellent workmanship: plastic culture dishes are ergonomically designed, with smooth surface, exquisite details and comfortable to use
- Easy to use: each culture dish has a lid and a smooth base, which can be stacked for easy storage
- Wide range of applications: plastic culture dishes are often used in schools and science laboratories, as well as medicine and biology, and are suitable for different types of scientific experiments and microbiology research
- Laboratory culture dishes: plastic culture dishes with lids are 70mm×15mm in size, compact and portable
Package List
20 * Plastic Petri Dishes
Features
- Size: Approx. 7 * 7 * 1.5cm/ 2.8 * 2.8 * 0.6 inch(L*W*H) agar plates.
- Material: Plastic ferrofluid.
- Color: Shown in the pictures ferrofluid speaker.
- Ergonomic designs with process plant kit.
- . Not easy to break transparent tape pipette clear tape clear duct tape agar ferrofluid agar plates Plastic Petri Dishes Disposal Petri Dishes Petri Dishes Tissue Culture Plate Lab Petri Dish Petri Clear Petri Dish Petri.
- Come with lid for convenient use Disposal Petri Dishes.
agar transparent tape petri dish petri dishes with agar pipets small dish specimen cups
- Lightweight for portable carry Petri Dishes.
specimen cups with
Goods Description
glass petri dish The precise design will its practicability in the work of highly performance.glass petri dishes with lids Great choice for expriement petri dish uses. Petri Dishes It's easy to use. Petri Dish This item is manufactured with with process
- Item Model Number: C92224ZG7AY07HRMW
- Unit count: 1.00 count
- Batteries Required?: No
- Finish: Chrome
- Part Number: C92224ZG7AY07HRMW
- Product dimensions: 7 x 7 x 1.5 cm; 200 Grams
- Country of origin: China
- Item Weight: 200 g
- Manufacturer: ULTECHNOVO
- Size: Size 3
- Number Of Pieces: 20
- Finish type: Chrome
- Included Components: storage holder
-
In Stock